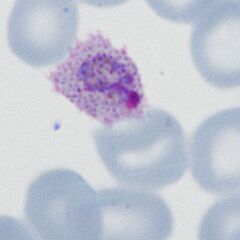

P.ovale late trophozoites gallery: Difference between revisions
From haematologyetc.co.uk
No edit summary |
No edit summary |
||
| Line 12: | Line 12: | ||
<span style="font-size:95%">'''Summary'''</span> | <span style="font-size:95%">'''Summary'''</span> | ||
<span style="font-size:95%">In contrast to ''P.vivax'', the late trophozoite stage of ''P.ovale'' | <span style="font-size:95%">In contrast to ''P.vivax'', the late trophozoite stage of ''P.ovale'' tend to retain a recognisable "ring" form for the parasites which become larger. However the rings may have some complexity of shape or become solid - so the distinction from ''P.vivax'' can still be difficult. James' dots will be prominent at this stage and malaria pigment will generally be seen. Often the most useful features is the the red cell is elongated and often has cytoplasmic fimbriation. Red cells end to be enlarged, but less so than the very large forms seen in ''P.vivax''. | ||
---- | ---- | ||
Latest revision as of 11:37, 7 May 2024
Navigation
Go Back
|